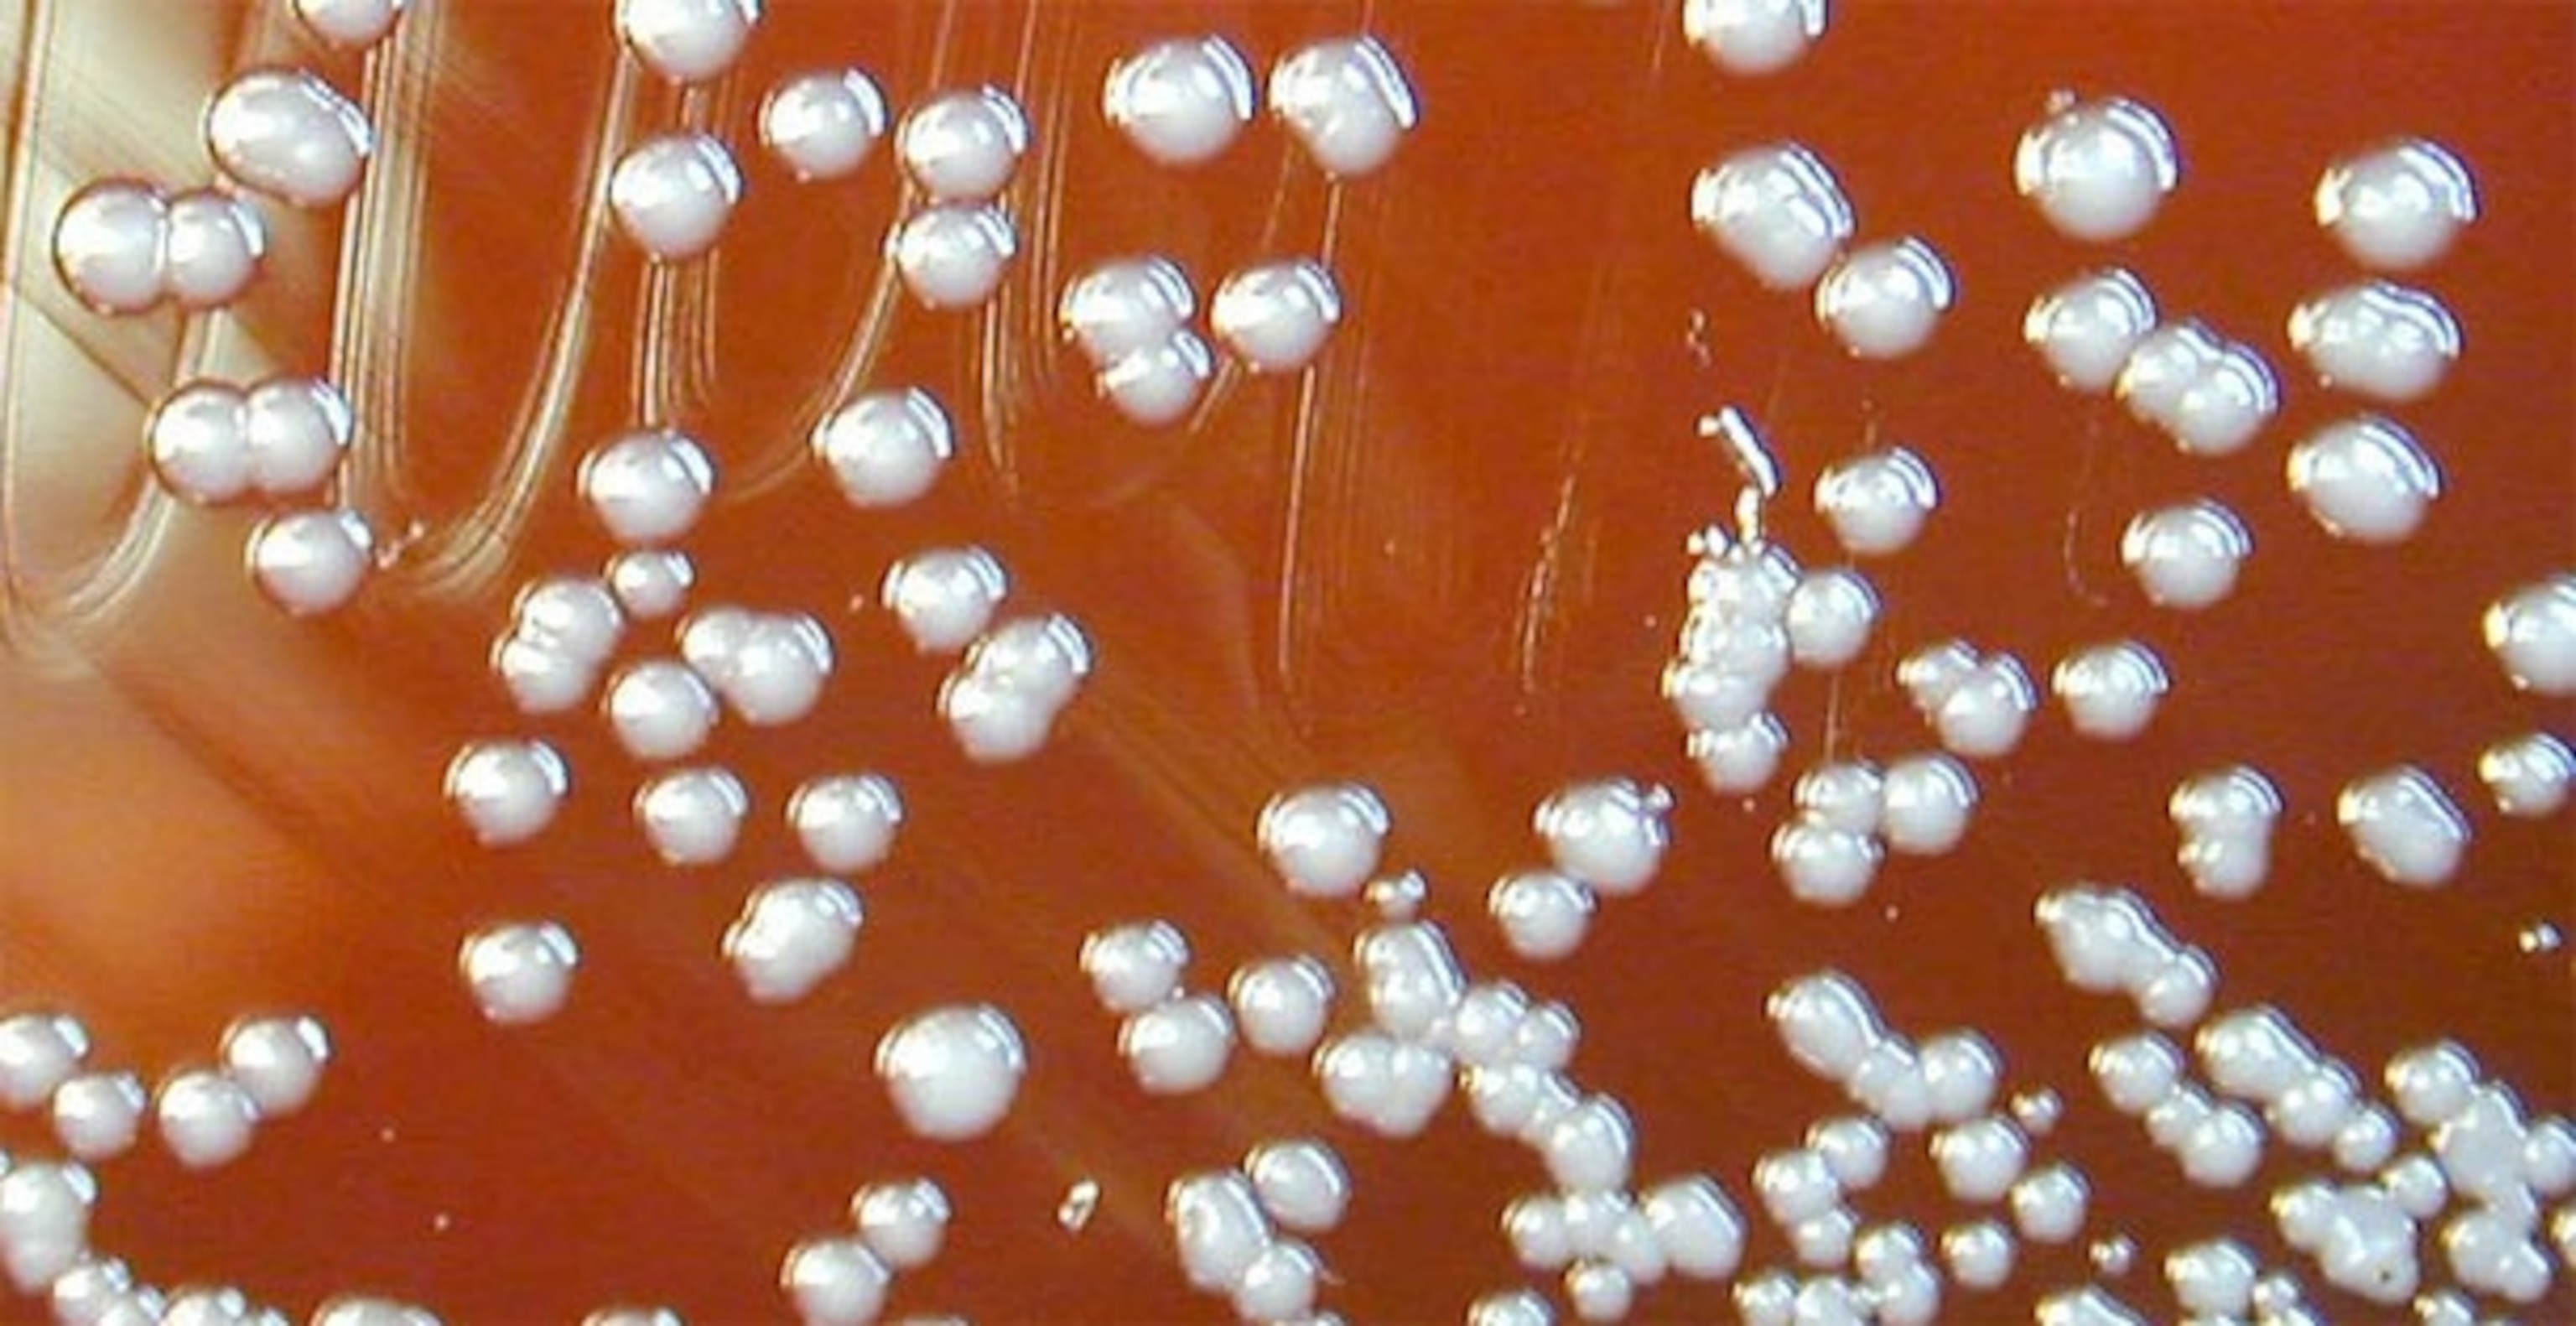

Scientists track the evolution of an epidemic to show how bacteria adapt
The bacteria that plague us during an infection are never quite the same as the ones that entered our body to begin with. With the ability to grow rapidly and swap genes, they can quickly adapt to our immune defences and the drugs we throw at them. Evolution is the greatest weapon that infectious bacteria wield, but Tami Lieberman and Jean-Baptiste Michel have found a way of turning it against them. They duo have shown that the same adaptations that make bacteria stronger can also reveal their weaknesses.
For years, Lieberman and Michel, both from Harvard Medical School, had been dreaming of following the evolution of a bacterial infection. They wanted to sequence the entire genomes of the microbes as they shifted in their host to work out which genes make them so good at causing disease, and which could be targeted by new medicines. Genetic technology had become so cheap and powerful that they knew they had the right tools. They just needed the bacteria.
Ideally, they were looking for people with infections like meningitis, which sometimes spread throughout the body. “We started a sample watch at several Harvard hospitals,” says Michel. “We said whenever you see bacterium X in a patient with disease Y, call us!” No one called. After much waiting, the duo realised that the samples they needed had been sitting in a freezer at Children’s Hospital Boston all along.
The samples came from a sad “natural experiment”. In the late 1990s, a small epidemic broke out among cystic fibrosis patients in the Boston area. This genetic disorder stops people from clearing mucus from their lungs and airways. As a result, otherwise harmless bacteria can cause debilitating and often lethal infections, which last for years or decades. The one that swept through Boston was a single strain of a previously unknown microbe called Burkholderia dolosa. It went on to affect 39 people and the epidemic lasted for 16 years.
The bug was so rare that the hospital staff collected and stored samples from 14 of the patients during the course of their care. Alex McAdam from Children’s Hospital Boston had these in his freezer, and he handed all 112 of them over. They included the most important samples of all: the ones from Patient Zero, the source of the epidemic. “That was exactly what we needed: repeated samples that would tell the evolutionary history of a bacterium evolving in patients over time,” says Michel.
Lieberman and Michel sequenced the entire genome of each sample, and built a family tree that plotted their evolutionary relationships. The tree confirmed that the epidemic was caused by a single strain. It showed Burkholderia’s route as it jumped from one host to another, and even from their lungs to their blood.
On its travels, the bacterium changed in several expected ways. For example, doctors will often treat cystic fibrosis patients with a group of antibiotics called fluoroquinolones. Some of the samples were twice as resistant to these drugs and others, and they all shared changes in a gene called gyrA. Only a few mutations in this gene conferred resistance, and each strain had acquired them independently. It seems that Burkholderia only has a few paths to drug resistance, but it can head down them with ease.
That was interesting, but predictable. Lieberman and Michel wanted more; they wanted to find the changes they weren’t expecting. They reasoned that bacteria like Burkholderia face similar challenges in different bodies, so the genes that are most critical for a successful infection will tend to change in similar ways. To find them, the duo searched their samples for genes that had independently acquired the same changes in different patients. They found dozens, but 17 in particular had built up three or more of the same mutations.
It was clear that these 17 are the subject of intense evolutionary pressure. Genes contain instructions for building proteins, and only some mutations change these instructions – the rest are neutral. In their select seventeen, Lieberman and Michel found that the important instruction-changing mutations outnumbered the neutral ones by 18 times. “We essentially asked the bacterium to tell us what genes are under selection in its natural environment: the human body,” says Michel.
Among these 17 genes, several did unsurprising jobs like resisting antibiotics. But six of them, including the most heavily mutated one, were unexpected culprits. They had never been implicated in disease before, and no one knows what they do. All we know, thanks to this study, is that they’re involved in infections. By studying this secret six, we can hopefully learn more about how Burkholderia gains a foothold in its hosts, and find new ways of treating it.
The study is delightfully unbiased. “We didn’t have to test for mutations in specific genes,” says Michel. “We simply discover where selection acts – sometimes in unexpected places. That tells us a lot about what life in the human body is like for bacteria, and it helps us figure out new ways to make it even harder for them.”
Other scientists have managed to look at how bacterial genes transform over time, including in people with cystic fibrosis. But they’ve found it more difficult to separate the important changes from the neutral ones. Lieberman says, “This was only possible because of the breadth and depth of our study.” If they hadn’t sequenced Burkholderia’s entire genome, they would have thought that all the samples were the same, and missed the subtle changes that characterised the microbe’s evolution. Likewise, if they’d looked at fewer samples, they wouldn’t have been able to find out which genes were under the strongest evolutionary pressure.
As genetic technology gets even cheaper, scientists could eventually use these techniques to study the evolution of an epidemic in real-time, or even the progress of a specific infection in a single patient. “I think we’re clearly heading this direction,” says Michel.
The main obstacle is knowledge, rather than technology. “We know so little about subtle genetic bacterial adaptation during disease that I’m not sure we’d be able to use such knowledge in the clinic immediately. What would we compare it to? This is where our study and others come in,” says Michel. Lieberman adds, “I hope our study will inspire an increase in the storage of clinical and environmental pathogen samples. The ability to apply these methods to other diseases will depend upon the richness of the available samples.”
PS: Michel’s name may be familiar to some eagle-eyed readers. He was one of the duo behind last year’s culturomics study, that looked at the evolution of cultural trends using Google Books.
Reference: Lieberman, Michel, Aingaran, Potter-Bynoe, Roux, Davis Jr, Skurnik, Leiby, LiPuma, Goldberg, McAdam, Priebe & Kishony. 2011. Parallel bacterial evolution within multiple patients identifies candidate pathogenicity genes. Nature Genetics. http://dx.doi.org/10.1038/ng.997
More on bacterial evolution:
- Our bodies are a global marketplace where bacteria trade genes
- Scientists sequence the full Black Death genome and find the mother of all plagues
- Bacteria: resisting antibiotics since at least 30,000 BC
- Fighting evolution with evolution – using viruses to target drug-resistant bacteria
- The real story about space bacteria
- Replaying evolution reveals the benefits of being slow and steady
- Gonorrhea has picked up human DNA (and that’s just the beginning)
